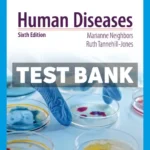
Human Diseases 6th Edition Neighbor Test Bank

Human Resource Management 17th Edition Valentine Test Bank
$65.00 Original price was: $65.00.$31.00Current price is: $31.00.
Enhance your study routine and prepare effectively with the “Human Resource Management 17th Edition Valentine Test Bank.” Designed specifically for students and educators, this comprehensive test bank is a valuable tool for mastering the core concepts of human resource management.
With expertly crafted questions and detailed answers, our test bank provides an unparalleled resource for evaluating your understanding of critical topics covered in the 17th edition of Human Resource Management by Valentine. Each test question is tailored to reinforce knowledge and boost confidence as you prepare for exams.
Available for instant download, this complete test bank is authentic and obtained directly from the publishers, ensuring you receive a reliable study aid to accompany your textbook. Covering all chapters, our test bank aligns seamlessly with the curriculum, offering precision and relevance in every question.
Unlock Your Academic Potential with Comprehensive Test Assessments
Optimize your study sessions and enhance your mastery of human resource management principles with our extensively compiled test bank. Transform the way you prepare for tests by utilizing this dependable and structured resource, specifically designed to meet your learning needs.
– Instantly downloadable for immediate use.
– Authentic content directly from the publishers.
– Comprehensive coverage of all textbook chapters.
– Reliable and expertly designed questions with correct answers.
– An ideal resource for both students and educators seeking to solidify their understanding and performance in HR management exams.


Reviews
There are no reviews yet.